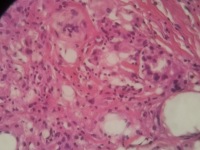

| 图片: | |
|---|---|
| 名称: | |
| 描述: | |
- 急!请老师帮忙看看,这个是脂肪坏死?
| 性别 | 女 | 年龄 | 31岁 | 临床诊断 | 左侧臀部肿物 |
|---|---|---|---|---|---|
| 一般病史 | 2个月前发现肿物,开始米粒大小,近几个月逐渐增大,触碰不适 | ||||
| 标本名称 | 左侧臀部肿物切除术 | ||||
| 大体所见 | 脂肪样组织4.2x1.9x0.6厘米,未见明显包膜,切开见囊腔,约2.4x1.3厘米,并见黄脓性粘稠物流出。 | ||||
标签:
×参考诊断